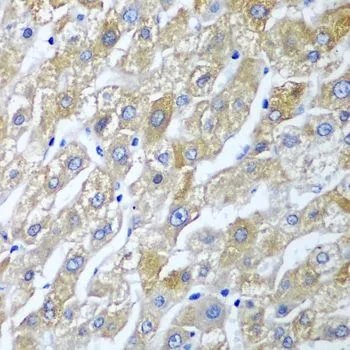

IHC-P analysis of human stomach tissue using GTX55796 SGSH antibody. Dilution : 1:100
SGSH antibody
GTX55796
ApplicationsWestern Blot, ImmunoHistoChemistry, ImmunoHistoChemistry Paraffin
Product group Antibodies
ReactivityHuman, Mouse
TargetSGSH
Overview
- SupplierGeneTex
- Product NameSGSH antibody
- Delivery Days Customer9
- Application Supplier NoteWB: 1:500 - 1:2000. IHC-P: 1:50 - 1:100. *Optimal dilutions/concentrations should be determined by the researcher.Not tested in other applications.
- ApplicationsWestern Blot, ImmunoHistoChemistry, ImmunoHistoChemistry Paraffin
- CertificationResearch Use Only
- ClonalityPolyclonal
- ConjugateUnconjugated
- Gene ID6448
- Target nameSGSH
- Target descriptionN-sulfoglucosamine sulfohydrolase
- Target synonymsHSS, MPS3A, SFMD, N-sulfoglucosamine sulfohydrolase, heparan sulfate sulfatase, mucopolysaccharidosis type IIIA, sulfoglucosamine sulfamidase, sulphamidase
- HostRabbit
- IsotypeIgG
- Protein IDP51688
- Protein NameN-sulphoglucosamine sulphohydrolase
- Scientific DescriptionThis gene encodes the enzyme sulfamidase; one of several enzymes involved in the lysosomal degradation of heparan sulfate. Mutations in this gene are associated with the lysosomal storage disease mucopolysaccaridosis IIIA, also known as Sanfilippo syndrome A, which results from impaired degradation of heparan sulfate. Transcripts of varying sizes have been reported but their biological validity has not been determined. [provided by RefSeq, Jun 2017]
- ReactivityHuman, Mouse
- Storage Instruction-20°C or -80°C,2°C to 8°C
- UNSPSC41116161